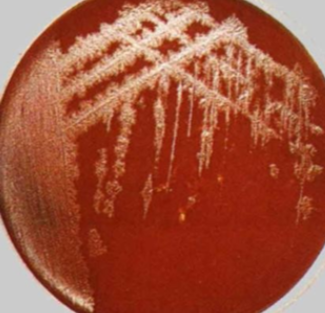
Рост бактерии на кровяном агаре

_______________________________________________________________________
Перепелкина Елизавета Андреевна
Московский государственный университет им. М.В.Ломоносова
Факультет биоинженерии и биоинформатики, 1 курс
_______________________________________________________________________
Clostridium tetani E88 - анаэробная, грамположительная, эндоспорообразующая, палочковидная бактерия, которая обитает преимущественно в почве. Вызывает столбняк - острое токсико-инфекционное заболевание с судорожно-паралитическим синдромом и высокой летальностью. Проведенные анализы генома бактерии подтверждают ее высокую патогенность.
Систематическое положение Clostridium tetani E88 [1]:
| Домен | Bacteria |
| Класс | Clostridia |
| Семейство | Clostridiaceae |
| Род | Clostridium |
| Вид | Clostridium tetani E88 |
Clostridium tetani E88 - грамположительная, спорообразующая, облигатно анаэробная бактерия рода Clostridium , возбудитель столбняка. Открыта в 1884г. немецким медиком Артуром Николайером, выделена в чистую культуру в 1889г. японским бактериологом Китасато Сибасабуро. Токсин отнесен ко II группе патогенности [2].
Морфология и анатомия клетки.
Крупная (3-12 х 0,3-0,6 мкм), палочковидная бактерия (рисунок 1) [2].

Подвижная - жгутики расположены перетрихиально (рисунок 2) [3].

В присутствии кислорода образует овальные эндоспоры, превышающие диаметр клетки в 2-3 раза, расположенные терминально (характерная морфология типа «барабанных палочек») (рисунок 3) [3].

Имеет толстую клеточную стенку, состоящую из нескольких слоев пептидогликана и одной внутренней мембраны [4].
Структура генома.
Геном Clostridium tetani E88 состоит из кольцевой хромосомы с 2799250 парами оснований, с содержанием G-C 28,6%. На хромосоме имеется 2368 открытых рамок считывания, при этом большинство генов, по-видимому, не функциональны. Это можно объяснить значительным горизонтальным переносом генов, о чем свидетельствует низкое содержание G-C. Единственная позиция на хромосоме, где содержание G-C близко к 50%, находится в генах, кодирующих рибосомные белки.
Плазмида pE88 состоит из 61 открытой рамки считывания, и только половину из них связана с определенными известными функциями. Три ОРС связаны с репликацией, семь - с регуляцией, девять - с транспортом, пять - с транспозицией, три - с пептидазой и одна - с рРНК-метилтрансферазой. Плазмида pE88 также содержит ген столбнячного токсина (tetX), а также ген фактора вирулентности, кодирующий коллагеназу (colT). Эти гены связаны с патогенезом Clostridium tetani E88 (рисунок 4) [3].

Экология.
Clostridium tetani встречается преимущественно в тёплых и влажных местах, особенно в почве, обработанной навозом, но может также быть обнаружена в кишечнике или фекалиях многих животных, таких как лошади, овцы и собаки. В вегетативном состоянии Clostridium tetani чувствительна к теплу и не может выживать в присутствии кислорода. Однако ее споры устойчивы к теплу и некоторым антисептикам, но богатые кислородом места также токсичны для них. В почве они могут сохраняться месяцами и даже годами при благоприятных условиях. Споры могут прорастать через мертвые клетки организма, распространяя токсины [4].
Культуральные свойства.
Хемоорганогетеротроф, облигатный анаэроб. Для культивирования на питательных средах необходимо обеспечивать анаэробные условия. На плотных питательных средах образуют мелкие прозрачные колонии с неправильными краями, через некоторое время приобретают стеклянный блеск (рисунок 5).
В жидких питательных средах растет медленно, наблюдается слабое помутнение и легкий слой пылевидного осадка на стенках пробирки (рисунок 6).

При уколе в толщу плотной питательной среды образует мелкие колонии, похожие на кусочки ваты. Разжижает желатин с газообразованием. Не ферментирует углеводов [2].
Патогенность.
Clostridium tetani E88 вырабатывает тетаноспазмин, обладающий нейротоксическими свойствами и тетанолизин, обладающий гемолитическими свойствами. Тетаноспазмин действует на периферическую нервную систему и вызывает тонические сокращения поперечно-полосатой мускулатуры. Тетанолизин вызывает лизис эритроцитов. Тетаноспазмин представляет собой одноцепочечный пептид (рисунок 7) [3].

Тетаноспазмин нейтрализуется противостолбнячной сывороткой, неустойчив при нагревании, в щелочной среде и под действием солнечных лучей. Не всасывается в пищеварительной системе, безопасен при пероральном приёме. Вызывает столбняк у человека, также патогенен для животных. Механизм передачи контактный [2].
Данные по геному бактерии Clostridium tetani E88 были взяты из следующих файлов: GCF_000007625.1_ASM762v1_cds_from_genomic.fna.gz (нуклеотидная последовательность репликонов), GCF_000007625.1_ASM762v1_feature_table.txt.gz (таблица особенностей генома бактерии Clostridium tetani E88). Файлы были взяты из базы данных NCBI (см. S1 в сопроводительных материалах).
Анализ длин белков проведен с помощью методов электронных таблиц Google sheets (см. S2 в сопроводительных материалах).
Анализ GC% проведен с помощью методов электронных таблиц Google sheets (см. S3 в сопроводительных материалах).
Анализ генов, кодирующих белки и разные типы РНК проведен с помощью методов электронных таблиц Google sheets (см. S4 в сопроводительных материалах).
Длины белков, закодированных в геноме бактерии Clostridium tetani E88 .

Исходя из гистограммы 1 можно сделать вывод, что большинство белков, закодированных в геноме данной бактерии, состоят из 100-350 аминокислот.
Исследование GC% по CDS в геноме бактерии Clostridium tetani E88 .

На гистограмме 2 представлено процентное содержание гуанина (G) и цитозина (C) среди всех нуклеотидов по CDS с шагом 2. Наиболее распространенны CDS с GC составом равным 26-32%. Редко встречаются CDS с составом GC 16-20% и 36-50%.
Количество генов белков и генов разных типов РНК для репликонов бактерии Clostridium tetani E88 .
У рассматриваемой бактерии имеется два репликона в геноме: единственная кольцевая хромосома (главная молекула ДНК) и одна плазмида. Для каждого репликона было подсчитано количество генов, кодирующих белки, и разные РНК (табл.1).
Таблица 1. Число генов, кодирующих белки и разные типы РНК, для каждого репликона бактерии Clostridium tetani E88 .
| |
|
|
|
|
|
|
| |
|
|
|
|
|
|
| |
|
|
|
|
|
|
Из таблицы видно, что данная бактерия имеет всего 2865 генов (2773 в главной хромосоме и 92 в плазмиде).
В геноме патогенных бактерий имеются участки ДНК протяженностью не менее 10000 пар нуклеотидов, которые отличаются от основного генома составом GC пар нуклеотидных оснований. Эти участки ответственны за синтез факторов патогенности, которые обеспечивают развитие патологического процесса в организме хозяина (острова патогенности). Большинство островов патогенности локализовано на хромосоме бактерии, но также они могут находиться в составе плазмиды.
Дальнейшее исследование предполагает анализ состава GC пар в плазмиде pE88 Clostridium tetani E88 . Если острова патогенности присутствуют в плазмиде pE88, то проведем сравнительный анализ количественного состава островов патогенности присутствующих в хромосоме Clostridium tetani E88 и ее плазмиде.
S1. База данных NCBI.
https://ftp.ncbi.nlm.nih.gov/genomes/all/GCF/000/007/625/GCF_000007625.1_ASM762v1
S2. Таблица длин белков.
https://docs.google.com/spreadsheets/d/1OSg9gq22nVW85vGaqCcnF_lanz0fYWLs_0yHr8WEPVo/edit?usp=sharing
S3. Таблица GC% генома бактерии.
https://docs.google.com/spreadsheets/d/1of2t3DhEjq6h5UMdB09iJkCXeUOsWxzOhi3dex_-u98/edit?usp=sharing
S4. Таблица генов, кодирующих белки и разные типы РНК.
https://docs.google.com/spreadsheets/d/1of2t3DhEjq6h5UMdB09iJkCXeUOsWxzOhi3dex_-u98/edit?usp=sharing
1. Clostridium tetani E88 (Электронный ресурс) | Virtual Laboratory Wiki | Fandom.
Режим доступа: https://vlab.fandom.com/ru/wiki/Clostridium_tetani_E88
2. Clostridium tetani (Электронный ресурс) | Virtual Laboratory Wiki | Fandom.
Режим доступа: https://vlab.fandom.com/ru/wiki/Clostridium_tetani
3. Литусов Н.В. Возбудитель столбняка. Иллюстрированное учебное пособие. – Екатеринбург: Изд-во ГБОУ ВПО УГМА, 2013. - 27 с.
4. Clostridium tetani (Электронный ресурс) - microbewiki.
Режим доступа: https://microbewiki.kenyon.edu/index.php/Clostridium_tetani